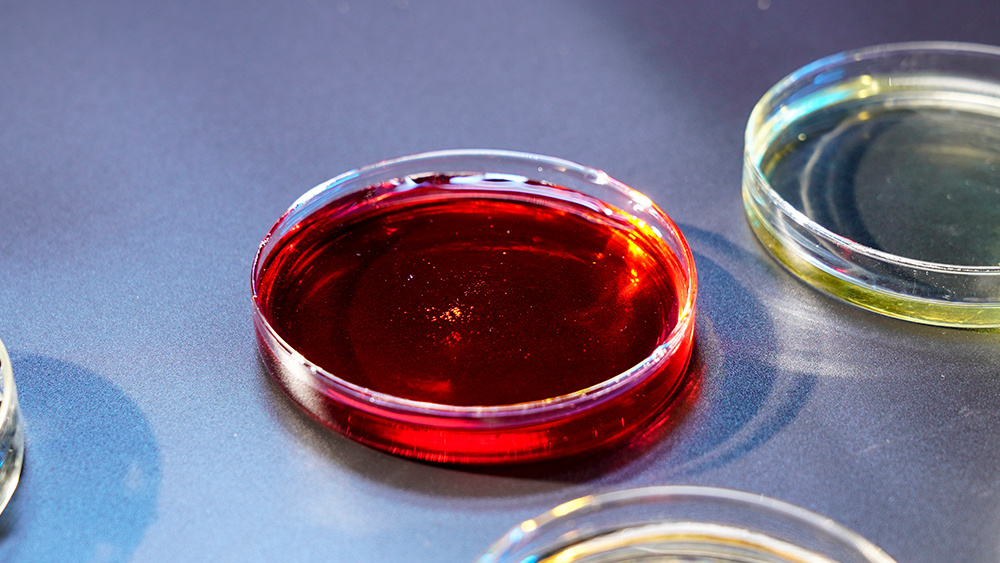

人才招聘
加入聖泉,讓未來屬于你自己!

耐火材料用酚醛樹脂
酚醛樹脂具有熱硬性,有高的殘炭,作爲耐火材料的接合劑,能(néng)夠提供足夠的結合強度。作爲國(guó)内領先的耐火材料用酚醛樹脂生産商,聖泉長(cháng)期緻力于酚醛樹脂的開(kāi)發(fā)和應用研究,不斷改進(jìn)酚醛樹脂的各項性能(néng),使其服務于衆多國(guó)内外企業。
0531-83511083産品概述
耐火材料用酚醛樹脂是用于耐火材料的樹脂産品,包括熱固性液體和熱塑性液體及熱塑性粉狀樹脂。該系列耐火材料用酚醛樹脂産品針對(duì)鋁碳和鎂碳材料的不同特性,設計不同結構及分子量,使之與堿性、中性耐火原料有良好(hǎo)的潤濕性能(néng),泥料可塑性好(hǎo),适合輪碾及高速混練工藝,根據客戶工藝可控制不同困料要求,打磚不易層裂。制備的耐火制品具有結合強度高、基質分散均勻,可滿足客戶不同工藝條件下的混料及成(chéng)型性能(néng)要求等特點。用于中間包幹式料的粉狀樹脂具有發(fā)煙量少、結合強度高、穩定性好(hǎo),不易結團等特點。
産品特點
聖泉耐火材料系列産品,針對(duì)各種(zhǒng)生産應用場合需求, 具有以下優勢::
-
多型号,對(duì)不同客戶的不同工藝需求有較強适應性;
-
易定制,可以根據客戶需求靈活調整産品;
-
嚴品控,保證正常産品的穩定性;
-
高保濕,降低樹脂使用量。
産品領域
适用于耐火材料,如鎂碳磚、鋁碳化矽碳磚,滑闆水口、連鑄三大件、搗打料、幹式料等。耐火材料用酚醛樹脂系列産品主要應用于鋼包鎂碳磚、轉爐鎂碳磚、鎂鋁碳磚、鋁碳化矽碳磚、滑闆水口、RH磚以及塞棒、長(cháng)水口、浸入式水口連鑄三大件等耐火材料制品。熱塑性液體酚醛樹脂系列産品主要應用于鋼包鎂碳磚、滑闆等耐火材料制品。熱塑性粉狀樹脂主要應用于鎂碳磚、滑闆、幹式料等耐火材料制品。
品質與服務
産品咨詢
如有疑問可直接熱線聯系:
400-777-8118
-
* 公司名稱
-
* 聯系電話
-
* 姓名
* 留言内容
濟南聖泉集團股份有限公司
地址:山東省章丘聖泉工業園
電話:400-666-8996
郵箱:web@shengquan.com
















